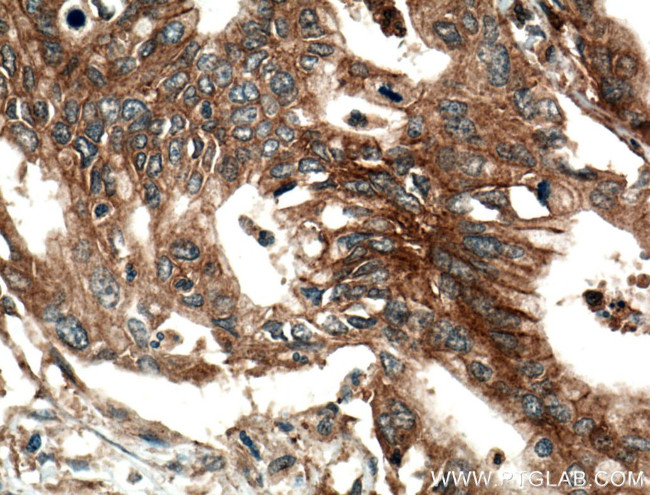
ADAM10 Antibody in Immunohistochemistry (Paraffin) (IHC (P))

Search
Proteintech
ADAM10 Polyclonal Antibody
{{$productOrderCtrl.translations['antibody.pdp.commerceCard.promotion.promotions']}}
{{$productOrderCtrl.translations['antibody.pdp.commerceCard.promotion.viewpromo']}}
{{$productOrderCtrl.translations['antibody.pdp.commerceCard.promotion.promocode']}}: {{promo.promoCode}} {{promo.promoTitle}} {{promo.promoDescription}}. {{$productOrderCtrl.translations['antibody.pdp.commerceCard.promotion.learnmore']}}
产品信息
25900-1-AP
种属反应
已发表种属
宿主/亚型
分类
类型
抗原
偶联物
形式
浓度
规格
纯化类型
保存液
内含物
保存条件
运输条件
产品详细信息
Immunogen sequence: EQNHDDYCL AYVFTDRDFD DGVLGLAWVG APSGSSGGIC EKSKLYSDGK KKSLNTGIIT VQNYGSHVPP KVSHITFAHE VGHNFGSPHD SGTECTPGES KNLGQKENGN YIMYARATSG DKLNNNKFSL CSIRNISQVL EKKRNNCFVE SGQPICGNGM VEQGEECDCG YSDQCKDECC FDANQPEGRK CKLKPGKQCS TVCIQVKV (306-512 aa encoded by BC126253)
靶标信息
Proinflammatory cytokine tumor necrosis factor-a (TNF-a) contributes to a variety of inflammatory responses and programmed cell death. Notch receptor and its ligand participate in cell fate decisions during vertebrate development and are associated with several human disorders, including a T-cell lymphoma. TNF-a, notch and its ligand delta are all membrane-bond molecules, which are cleaved by proteases to release mature proteins or functional receptor. ADAM10, a metalloprotease-disintegrin in the family of mammalian ADAM (for a disintegrin and metalloprotease), was recently identified to cleave TNF-a, notch and its ligand delta (1-3). The genes encoding human, mouse, and bovine ADAM10 were recently cloned and designated ADAM 10, kuzbanian (KUZ), and MADM, respectively. ADAM10 mRNA is expressed in a variety of human and bovine tissues.
仅用于科研。不用于诊断过程。未经明确授权不得转售。
生物信息学
蛋白别名: a disintegrin and metalloprotease domain (ADAM) 10; a disintegrin and metalloprotease domain 10; a disintegrin and metalloproteinase; ADAM; ADAM 10; ADAMs; CD156c; CDw156; Disintegrin and metalloproteinase domain-containing protein 10; Kuzbanian protein homolog; Mammalian disintegrin-metalloprotease; metalloendopeptidases; unnamed protein product
基因别名: 1700031C13Rik; AD10; AD18; ADAM10; CD156c; CDw156; HsT18717; KUZ; kuzbanian; MADM; RAK
UniProt ID: (Human) O14672, (Mouse) O35598
Entrez Gene ID: (Human) 102, (Mouse) 11487